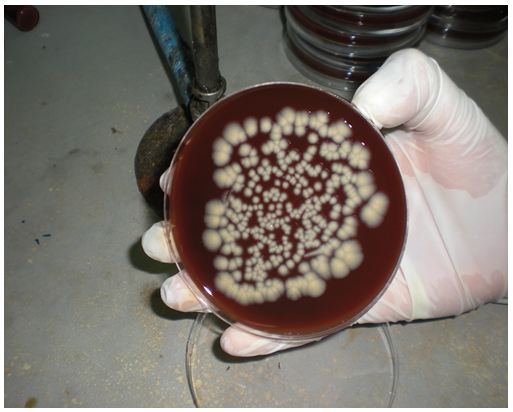
Figure 27 Helicobacter pylori Etude bactériologique des premières souches isolées à l’Hôpital Bologhine Ibn Ziri Figure 27 Helicobacter pylori Etude bactériologique des premières souches isolées à l’Hôpital Bologhine Ibn Ziri
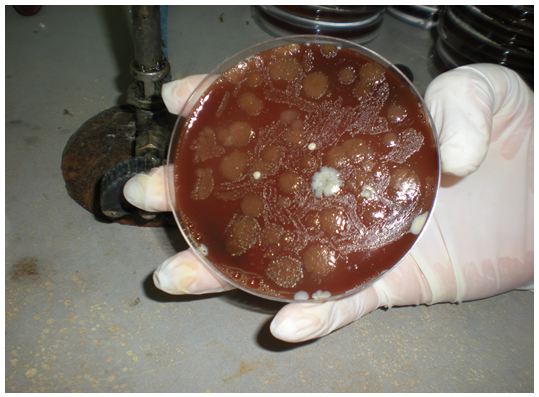
Figure 28 Helicobacter pylori Etude bactériologique des premières souches isolées à l’Hôpital Bologhine Ibn Ziri Figure 28 Helicobacter pylori Etude bactériologique des premières souches isolées à l’Hôpital Bologhine Ibn Ziri

Tableau XII : Pourcentage de positivité de la culture.
On note un taux de positivité à la culture de 34,3% ce qui concorde avec le taux de positivité rapporté au nombre de patients (34,2%). Sur les 38 cas adressés, 13 souches ont été identifiées et seules 10 ont pu être isolées et purifiées (Figure n°26). En effet pour trois des patients, une contamination importante à rendu les cultures inexploitables (Figure n°27). Ceci s’explique par des contaminants pouvant provenir du matériel d’endoscopie, de la flore oro-pharyngée des patients, des poches de sang servant la préparation des milieux de culture, ou de l’environnement (matériel, manipulateur, ambiance). Il est à noter également que ces bactéries contaminantes sont forcément résistantes aux différents antibiotiques contenus dans le milieu de culture spécifique à Helicobacter pylori.
Lors de notre étude, nous avons remarqué que pour un patient dont on traite les deux prélèvements (antral et fundique), la positivité est retrouvé pour les deux sites.
Figure n°26 : Réisolement de Helicobacter pylori (Photo prise au laboratoire de bactériologie de l’EPH Bologhine).
Figure n°27 : Contamination d’une primo culture de Helicobacter pylori (Photo prise au laboratoire de bactériologie de l’EPH Bologhine).
Figure n° 28: Contamination d’un réisolement de Helicobacter pylori (Photo prise au laboratoire de bactériologie de l’EPH Bologhine).